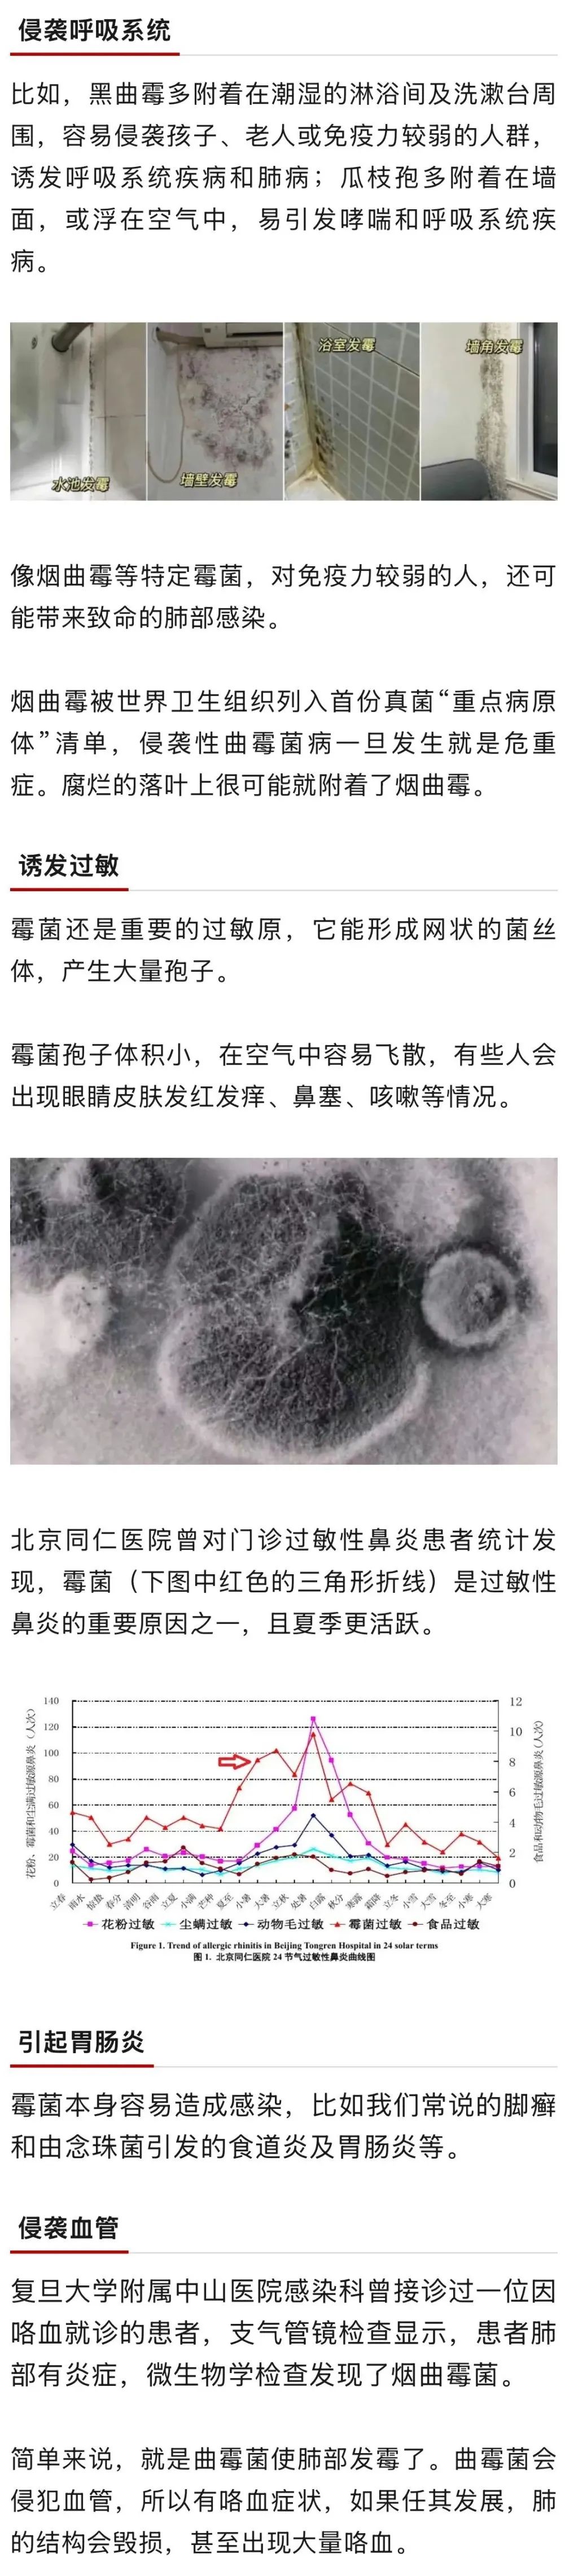
图片

你家里有没有这种小黑点?这种小黑点,其实是小霉点,由霉菌造成。霉菌不仅影响美观,还对人体呼吸系统、皮肤、肠道等有潜在威胁。家中哪些地方容易藏匿霉菌?如何应对?今天就来讲清楚。
夏天是霉菌活跃的季节
霉菌,是一种特殊的真菌,能够引起霉变反应。霉菌有数万种,其中有30种左右寄居在家里,最常见的室内霉菌是枝孢菌、青霉菌和曲霉菌。
有的霉菌有潜在致癌风险,比如黄曲霉菌能分泌黄曲霉毒素,这种毒素的毒性是砒霜的几十倍。
一般来说,温度20℃~35℃、相对湿度75%以上,比较适合霉菌生长。其中,“梅雨天”霉菌的滋生速度是其他季节的4倍。
出现小霉点,伤害一连串
家里出现小霉点,对健康有潜在威胁,其危害很多人忽视了。
霉菌爱藏在5个地方
霉菌大量繁殖主要有4个条件:①温度超过20℃;②湿度70%以上;③垃圾和灰尘等为其提供“营养源”;④氧气充足。基于霉菌的生存条件,家里以下地方更容易藏匿霉菌。

家里出现霉菌如何清除?
霉菌通常可通过高温(水温80℃以上、阳光暴晒等)、按说明书配置84消毒液(不要和洁厕灵等清洁剂混用)等方式杀灭。
对于墙体发霉,北京清洁协会专家张永红表示,如果霉点不严重,可用抹布直接擦掉,也可用漂白水喷雾(有颜色的墙面慎用);如为墙纸,不能用水擦,要用布浸点酒精抹拭。
霉菌滋生受温度、湿度影响,保持清洁和干燥,是解决霉菌问题的关键。生活中可注意以下几点:
1.关注重点场所
尤其是空调、水槽排水孔、冰箱底盘、菜板、浴缸或瓷砖缝、窗边、墙壁、天花板、植物盆栽等地方。
2.适当除湿
控好湿度能减少霉菌滋生。
雨季可适当使用除湿机,或打开空调的除湿模式;
可以准备一湿一干两个拖布,并尽量用干拖布将地面擦干;
洗澡后开启换气扇,并及时清理地上的水;
室外较潮湿时,少开门窗。
3.经常通风
保持家中通风良好,浴室尽量安装换气设备。经常通气还能稀释空气中的霉菌孢子,降低潜在危害。需要提醒的是,在进行除霉操作时,最好佩戴手套、口罩,并开窗通风。